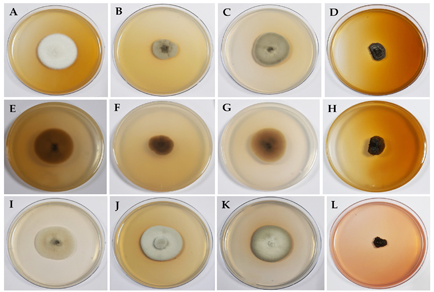

Abstract
Endophytic fungi inhabit internal plant tissues without causing disease, often forming complex and beneficial associations with their hosts. As part of a study on the endophytic fungal diversity of Azadirachta indica (neem) from the Deccan Plateau, India, two greyish white fungal isolates with moderate growth rate were obtained from the petiole and lamina of healthy neem leaves. Morphological traits and culture characteristics of both isolates suggested their affiliation with the genus Nigrograna (Pleosporales, Ascomycota). To resolve their taxonomic position, comprehensive morphological examinations were coupled with multilocus phylogenetic analyses using ITS, LSU, SSU, rpb2, and tef-1α gene regions. Both isolates clustered together in a distinct, well-supported clade, clearly separated from known Nigrograna taxa. Based on consistent morphological, cultural features and robust molecular evidence, we propose these isolates as representing a novel species, Nigrograna sunildeshmukhii sp. nov. This study constitutes the first report of a Nigrograna species associated with A. indica and contributes to the expanding diversity of endophytic fungi from the ecologically significant Deccan Plateau. The isolation of the same species from both petiole and lamina regions also suggests tissue versatility and ecological adaptation within the host.
References
- Aamir, S., Sutar, S., Singh, S.K. & Baghela, A. (2015) A rapid and efficient method of fungal genomic DNA extraction, suitable for PCR based molecular methods. Plant Pathology and Quarantine 5: 74–81. https://doi.org/10.5943/ppq/5/2/6
- Ahmed, S., González, G., Tirado‐Sánchez, A., Moreno‐López, L., Hoog, S. & Bonifáz, A. (2018) Nigrograna mackinnonii, not Trematosphaeria grisea (syn., Madurella grisea), is the main agent of black grain Eumycetoma in Latin america. Journal of Clinical Microbiology 56 (3): e01723–17. https://doi.org/10.1128/JCM.01723-17
- Ahmed, S.A., van de Sande, W.W.J., Stevens, D.A., Fahal, A., van Diepeningen, A.D., Menken, S.B.J. & de Hoog, G.S. (2014) Revision of agents of black-grain eumycetoma in the order pleosporales. Persoonia—Molecular Phylogeny and Evolution of Fungi 33 (1): 141–154. https://doi.org/10.3767/003158514X684744
- An, C., Ma, S., Shi, X., Xue, W., Liu, C. & Ding, H. (2020) Diversity and antimicrobial activity of endophytic fungi isolated from Chloranthus japonicus Sieb in Qinling mountains, China. International Journal of Molecular Sciences 21 (17): 5958. https://doi.org/10.3390/ijms21175958
- Bills, G.F. & Polishook, J.D. (1992) Recovery of endophytic fungi from Chamaecyparis thyoides. Sydowia 44: 1–12.
- Boonmee, S., Wanasinghe, D.N., Calabon, M.S., Huanraluek, N., Chandrasiri, S.K.U., Jones, G.E.B., Rossi, W., Leonardi, M., Singh, S.K., Rana, S., Singh, P.N., Maurya, D.K., Lagashetti, A.C., Choudhary, D., Dai, Y.C., Zhao, C.L., Mu, Y.H., Yuan, H.S., He, S.H., Phookamsak, R., Jiang, H.B., Martín, M.P., Dueñas, M., Telleria, M.T., Kałucka, I.L., Jagodziński, A.M., Liimatainen, K., Pereira, D.S., Phillips, A.J.L., Suwannarach, N., Kumla, J., Khuna, S., Lumyong, S., Potter, T.B., Shivas, R.G., Sparks, A.H., Vaghefi, N., Abdel-Wahab, M.A., Abdel-Aziz, F.A., Li, G.J., Lin, W.F., Singh, U., Bhatt, R.P., Lee, H.B., Nguyen, T.T.T., Kirk, P.M., Dutta, A.K., Acharya, K., Sarma, V.V., Niranjan, M., Rajeshkumar, K.C., Ashtekar, N., Lad, S., Wijayawardene, N.N., Bhat, D.J., Xu, R.J., Wijesinghe, S.N., Shen, H.W., Luo, Z.L., Zhang, J.Y., Sysouphanthong, P., Thongklang, N., Bao, D.F., Aluthmuhandiram, J.V.S., Abdollahzadeh, J., Javadi, A., Dovana, F., Usman, M., Khalid, A.N., Dissanayake, A.J., Telagathoti, A., Probst, M., Peintner, U., Garrido-Benavent, I., Bóna, L., Merényi, Z., Boros, L., Zoltán, B., Stielow, J.B., Jiang, N., Tian, C.M., Shams, E., Dehghanizadeh, F., Pordel, A., Javan-Nikkhah, M., Denchev, T.T., Denchev, C.M., Kemler, M., Begerow, D., Deng, C.Y., Harrower, E., Bozorov, T., Kholmuradova, T., Gafforov, Y., Abdurazakov, A., Xu, J.C., Mortimer, P.E., Ren, G.C., Jeewon, R., Maharachchikumbura, S.S.N., Phukhamsakda, C., Mapook, A. & Hyde, K.D. (2021) Fungal diversity notes 1387–1511: Taxonomic and phylogenetic contributions on genera and species of fungal taxa. Fungal Diversity 111: 1–335. https://doi.org/10.1007/s13225-021-00489-3
- Bundhun, D., Jayawardena, R.S. & Camporesi, E. (2023) Introducing Nigrograna italica sp. nov. (Nigrogranaceae) from Corylus avellana and Valsaria tectonae sp. nov. (Valsariaceae) from Tectona grandis. Phytotaxa 618 (2): 103–119. https://doi.org/10.11646/phytotaxa.618.2.1
- Chutulo, E. & Chalannavar, R. (2018) Endophytic mycoflora and their bioactive compounds from Azadirachta indica: a comprehensive review. Journal of Fungi 4 (2): 42. https://doi.org/10.3390/jof4020042
- Dayarathne, M.C., Jones, E.B.G., Maharachchikumbura, S.S.N., Devadatha, B., Sarma, V.V., Khongphinitbunjong, K., Chomnunti, P. & Hyde, K.D. (2020) Morpho-molecular characterization of microfungi associated with marine based habitats. Mycosphere 11 (1): 1–188. https://doi.org/10.5943/mycosphere/11/1/1
- de Gruyter, J., Woudenberg, J.H., Aveskamp, M.M., Verkley, G.J., Groenewald, J.Z. & Crous, P.W. (2013) Redisposition of Phoma-like anamorphs in Pleosporales. Studies in mycology 75 (1): 1–36. https://doi.org/10.3114/sim0004
- Dobranic, J.K., Johnson, J.A. & Alikhan, Q.R. (1995) Isolation of endophytic fungi from eastern larch (Larix laricina) leaves from New Brunswick, Canada. Canadian Journal of Microbiology 41: 194–198. https://doi.org/10.1139/m95-026
- Dong, W., Wang, B., Hyde, K.D., McKenzie, E.H.C., Raja, H.A., Tanaka, K., Abdel-Wahab, M.A., Abdel-Aziz, F.A., Doilom, M., Phookamsak, R., Hongsanan, S., Wanasinghe, D.N., Yu, X.D., Wang, G.N., Yang, H., Yang, J., Thambugala, K.M., Tian, Q., Luo, Z.L., Yang, J.B., Miller, A.N., Fournier, J., Boonmee, S., Hu, D.M., Nalumpang, S. & Zhang, H. (2020) Freshwater Dothideomycetes. Fungal Diversity 105: 319–575. https://doi.org/10.1007/s13225-020-00463-5
- Du, H.Z., Lu, Y.H., Cheewangkoon, R. & Liu, J.K. (2024a) Morpho-phylogenetic evidence reveals novel species and new records of Nigrograna (Nigrogranaceae) associated with medicinal plants in Southwestern China. MycoKeys 110: 1–33. https://doi.org/10.3897/mycokeys.110.132628
- Du, T.Y., Tibpromma, S., Hyde, K.D., Mapook, A., Dai, D.Q., Zhang, G.Q., Stephenson, S.L., Suwannarach, N., Kumla, J., Elgorban, A.M., Rajeshkumar, K.C., Maharachchikumbura, S.S.N., Li, Q. & Karunarathna, S.C. (2024b) The polyphasic approach reveals ten novel and one known Ascomycota taxa from terrestrial agarwood-producing trees. Journal of Systematics and Evolution 63 (2): 431–468. https://doi.org/10.1111/jse.13128
- Gnavi, G., Ercole, E., Panno, L., Vizzini, A. & Varese, G. (2014) Dothideomycetes and Leotiomycetes sterile mycelia isolated from the Italian seagrass Posidonia oceanica based on rDNA data. Springerplus 3: 508. https://doi.org/10.1186/2193-1801-3-508
- Hu, H., He, M., Wu, Y., Long, S., Zhang, X., Liu, L., Shen, X., Wijayawardene, N.N., Meng, Z., Long, Q., Kang, J. & Li, Q. (2023) Taxonomic and phylogenetic characterisations of six species of Pleosporales (in Didymosphaeriaceae, Roussoellaceae and Nigrogranaceae) from China. MycoKeys 100: 123–151. https://doi.org/10.3897/mycokeys.100.109423
- Hughart, R., Merrick, M., Adelaja, O., Bleasdale, S., Harrington, A. & Tsoukas, M. (2016) Cutaneous Phaeohyphomycosis caused by Biatriospora mackinnonii in a renal transplant recipient. Jaad Case Reports 2 (3): 230–232. https://doi.org/10.1016/j.jdcr.2016.03.015
- Hyde, K.D., Norphanphoun, C., Ma, J., Yang, H.D., Zhang, J.Y., Du, T.Y., Gao, Y., Gomes de Farias, A., He, S.C., He, Y.K., Li, C.J.Y., Liu, X.F., Lu, L.L., Su, H.L., Tang, X., Tian, X.G., Wang, S.Y., Wei, D.P., Xu, R.F., Xu, R.J., Yang, Y., Yang, Y.Y., Zhang, F., Zhang, Q., Bahkali, A., Boonmee, S., Chethana, K., Jayawardena, R., Lu, Y.Z., Karunarathna, S., Tibpromma, S. & Wang, Y. (2023) Mycosphere notes 387–412—novel species of fungal taxa from around the world. Mycosphere 14 (1): 663–744. https://doi.org/10.5943/mycosphere/14/1/8
- Hyde, K.D., Norphanphoun, C., Abreu, V.P., Bazzicalupo, A., Chethana, K.W.T., Clericuzio, M., Dayarathne, M.C., Dissanayake, A.J., Ekanayaka, A.H., He, M.Q., Hongsanan, S., Huang, S.K., Jayasiri, S.C., Jayawardena, R.S., Karunarathna, A., Konta, S., Kušan, I., Lee, H., Li, J., Lin, C.G., Liu, N.G., Lu, Y.Z., Luo, Z.L., Manawasinghe, I.S., Mapook, A., Perera, R.H., Phookamsak, R., Phukhamsakda, C., Siedlecki, I., Soares, A.M., Tennakoon, D.S., Tian, Q., Tibpromma, S., Wanasinghe, D.N., Xiao, Y.P., Yang, J., Zeng, X.Y., Abdel-Aziz, F.A., Li, W.J., Senanayake, I.C., Shang, Q.J., Daranagama, D.A., de Silva, N.I., Thambugala, K.M., Abdel-Wahab, M.A., Bahkali, A.H., Berbee, M.L., Boonmee, S., Bhat, D.J., Bulgakov, T.S., Buyck, B., Camporesi, E., Castañeda-Ruiz, R.F., Chomnunti, P., Doilom, M., Dovana, F., Gibertoni, T.B., Jadan, M., Jeewon, R., Jones, E.B.G., Kang, J.C., Karunarathna, S.C., Lim, Y.W., Liu, J.K., Liu, Z.Y., Plautz Jr., H.L., Lumyong, S., Maharachchikumbura, S.S.N., Matočec, N., McKenzie, E.H.C., Mešić, A., Miller, D., Pawłowska, J., Pereira, O.L., Promputtha, I., Romero, A.I., Ryvarden, L., Su, H.Y., Suetrong, S., Tkalčec, Z., Vizzini, A., Wen, T.C., Wisitrassameewong, K., Wrzosek, M., Xu, J.C., Zhao, Q., Zhao, R.L. & Mortimer, P.E. (2017) Fungal diversity notes 603–708: taxonomic and phylogenetic notes on genera and species. Fungal Diversity 87: 1–235. https://doi.org/10.1007/s13225-017-0391-3
- Jaklitsch, W.M. & Voglmayr, H. (2016) Hidden diversity in Thyridaria and a new circumscription of the Thyridariaceae. Studies in mycology 85: 35–64. https://doi.org/10.1016/j.simyco.2016.09.002
- Jia, M., Chen, L., Xin, H.L., Zheng, C.J., Rahman, K., Han, T. & Qin, L.P. (2016) A friendly relationship between endophytic fungi and medicinal plants: a systematic review. Frontiers in Microbiology 7: 906. https://doi.org/10.3389/fmicb.2016.00906
- Kalyaanamoorthy, S., Minh, B.Q., Wong, T.K.F., von Haeseler, A. & Jermiin, L.S. (2017) ModelFinder: Fast model selection for accurate phylogenetic estimates. Nature Methods 14: 587. https://doi.org/10.1038/nmeth.4285
- Katoh, K. & Standley, D.M. (2013) MAFFT Multiple sequence alignment software version 7: Improvements in performance and usability. Molecular Biology and Evolution 30: 772–780. https://doi.org/10.1093/molbev/mst010
- Kolařík, M. (2018) New taxonomic combinations in endophytic representatives of the genus Nigrograna. Czech Mycology 70 (2): 123–126. https://doi.org/10.33585/cmy.70202
- Kolařík, M., Spakowicz, D.J., Gazis, R., Shaw, J., Kubátová, A., Nováková, A., Chudíčková, M., Forcina, G.C., Kang, K.W., Kelnarová, I., Skaltsas, D., Portero, C.E., Strobel, S.A. & Narváez-Trujillo, A. (2017) Biatriospora (Ascomycota: Pleosporales) is an ecologically diverse genus including facultative marine fungi and endophytes with biotechnological potential. Plant Systematics and Evolution 303: 35–50. https://doi.org/10.1007/s00606-016-1350-2
- Kornerup, A. & Wanscher, J.H. (1978) Metheun’s Handbook of colours, IIIrd Ed. Metheun and Co. Ltd., London, 252 pp.
- Li, W., Liang, R., Dissanayake, A. & Liu, J. (2023) Mycosphere Notes 413–448: Dothideomycetes associated with woody oil plants in China. Mycosphere 14 (1): 1436–1529. https://doi.org/10.5943/mycosphere/14/1/16
- Liu, S.L., Wang, X.W., Li, G.J., Deng, C.Y., Rossi, W., Leonardi, M., Liimatainen, K., Kekki, T., Niskanen, T., Smith, M.E., Ammirati, J., Bojantchev, D., Abdel-Wahab, M.A., Zhang, M., Tian, E., Lu, Y.Z., Zhang, J.Y., Ma, J., Dutta, A.K., Acharya, K., Du, T.Y., Xu, J., Kim, J.S., Lim, Y.W., Gerlach, A., Zeng, N.K., Han, Y.X., Razaghi, P., Raza, M., Cai, L., Calabon, M.S., Jones, E.B.G., Saha, R., Kumar, T.K.A., Krishnapriya, K., Thomas, A., Kaliyaperumal, M., Kezo, K., Gunaseelan, S., Singh, S.K., Singh, P.N., Lagashetti, A.C., Pawar, K.S., Jiang, S., Zhang, C., Zhang, H., Qing, Y., Bau, T., Peng, X.C., Wen, T.C., Ramirez, N.A., Niveiro, N., Li, M.X., Yang, Z.L., Wu, G., Tarafder, E., Tennakoon, D.S., Kuo, C.H., da Silva, T.M., Souza-Motta, C.M., Bezerra, J.D.P., He, G., Ji, X.H., Suwannarach, N., Kumla, J., Lumyong, S., Wannathes, N., Rana, S., Hyde, K.D. & Zhou, L.W. (2024) Fungal diversity notes 1717–1817: Taxonomic and phylogenetic contributions on genera and species of fungal taxa. Fungal Diversity 124: 1–216. https://doi.org/10.1007/s13225-023-00529-0
- Liu, Y.J.J., Whelen, S. & Benjamin, D.H. (1999) Phylogenetic relationships among ascomycetes: Evidence from an RNA polymerase II subunit. Molecular Biology and Evolution 16: 1799–1808. https://doi.org/10.1093/oxfordjournals.molbev.a026092
- Lu, L., Karunarathna, S.C., Dai, D., Jayawardena, R.S., Suwannarach, N. & Tibpromma, S. (2022) Three new species of Nigrograna (Dothideomycetes, Pleosporales) associated with Arabica coffee from Yunnan Province, China. MycoKeys 94: 51–71. https://doi.org/10.3897/mycokeys.94.95751
- Mack, J.N., Sproule, A., Shields, S.W., Seifert, K.A., Smith, M. & Overy, D.P. (2024) Two novel Pleosporales species isolated from the bark of Acer saccharum. Fungal Systematics and Evolution 13: 1–14. https://doi.org/10.3114/fuse.2024.13.01
- Mapook, A., Hyde, K.D., McKenzie, E.H.C., Jones, E.B.G., Bhat, D.J., Jeewon, R., Stadler, M., Samarakoon, M.C., Malaithong, M., Tanunchai, B., Buscot, F., Wubet, T. & Purahong, W. (2020) Taxonomic and phylogenetic contributions to fungi associated with the invasive weed Chromolaena odorata (Siam weed). Fungal Diversity 101: 1–175. https://doi.org/10.1007/s13225-020-00444-8
- Nguyen, L.T., Schmidt, H.A., von Haeseler, A. & Minh, B.Q. (2015) IQ-TREE: A fast and effective stochastic algorithm for estimating maximum-likelihood phylogenies. Molecular Biology and Evolution 32: 268–274. https://doi.org/10.1093/molbev/msu300
- Nisa, H., Kamili, A., Nawchoo, I., Shafi, S., Shameem, N. & Bandh, S. (2015) Fungal endophytes as prolific source of phytochemicals and other bioactive natural products: a review. Microbial Pathogenesis 82: 50–59. https://doi.org/10.1016/j.micpath.2015.04.001
- Rakshit, S. & Sarma, V.V. (2025) Nigrograna andamanica sp. nov. from mangroves of Andaman Islands, India and keys for delineation of different species of Nigrograna. Mycological Progress 24: 24. https://doi.org/10.1007/s11557-025-02043-w
- Rana, S., Singh, S.K. & Dufossé, L. (2022) Multigene phylogeny, beauvericin production and bioactive potential of Fusarium strains isolated in India. Journal of Fungi 8 (7): 662. https://doi.org/10.3390/jof8070662
- Rehner, S.A. & Buckley, E. (2005) A Beauveria phylogeny inferred from nuclear ITS and EF1-alpha sequences: evidence for cryptic diversification and links to Cordyceps teleomorphs. Mycologia 97 (1): 84–98. https://doi.org/10.3852/mycologia.97.1.84
- Ren, G.C., Jayasiri, S.C., Tibpromma, S., De Farias, A.R.G., Chethana, K.W.T., Faraj, K.H., Wanasinghe, D.N., Xu, J.C., Hyde, K.D. & Gui, H. (2024) Saprobic ascomycetes associated with woody litter from the Greater Mekong Subregion (Southwestern China and Northern Thailand). Mycosphere 15 (1): 954–1082. https://doi.org/10.5943/mycosphere/15/1/8
- Senanayake, I.C., Rossi, W., Leonardi, M., Weir, A., McHugh, M., Rajeshkumar, K.C., Verma, R.K., Karunarathna, S.C., Tibpromma, S., Ashtekar, N., Ashtamoorthy, S.K., Raveendran, S., Kour, G., Singh, A., De la Peña-Lastra, S., Mateos, A., Kolařík, M., Antonín, V., Ševčíková, H., Esteve-Raventós, F., Larsson, E., Pancorbo, F., Moreno, G., Altés, A., Turégano, Y., Du, T.Y., Lu, L., Li, Q.R., Kang, J.C., Gunaseelan, S., Kezo, K., Kaliyaperumal, M., Fu, J., Samarakoon, M.C., Gafforov, Y., Teshaboeva, S., Kunjan, P.C., Chamaparambath, A., Flakus, A., Etayo, J., Rodriguez-Flakus, P., Zhurbenko, M.P., de Silva, N.I., Tennakoon, D.S., Latha, K.P.D., Manimohan, P., Raj, K.N.A., Calabon, M.S., Ahmadpour, A., Heidarian, Z., Alavi, Z., Alavi, F., Ghosta, Y., Azizi, R., Luo, M., Zhao, M.P., Kularathnage, N.D., Hua, L., Yang, Y.H., Liao, C.F., Zhao, H.J., Lestari, A.S., Jayasiri, S.C., Yu, F.M., Lei, L., Liu, J.W., Karimi, O., Tang, S.M., Sun, Y.R., Wang, Y., Zeng, M., Htet, Z.H., Linaldeddu, B.T., Alves, A., Phillips, A.J.L., Bregant, C., Montecchio, L., De Kesel, A., Hustad, V.P., Miller, A.N., Fedosova, A.G., Kučera, V., Raza, M., Hussain, M., Chen, Y.P., Thiyagaraja, V., Gomdola, D., Rathnayaka, A.R., Dissanayake, A.J., Suwannarach, N., Hongsanan, S., Maharachchikumbura, S.S.N., Dissanayake, L.S., Wijayawardene, N.N., Phookamsak, R., Lumyong, S., Jones, E.B.G., Yapa, N., Wanasinghe, D.N., Xie, N., Doilom, M., Manawasinghe, I.S., Liu, J.K., Zhao, Q., Xu, B., Hyde, K.D. & Song, J. (2023) Fungal diversity notes 1611–1716: taxonomic and phylogenetic contributions on fungal genera and species emphasis in south China. Fungal Diversity 122: 161–403. https://doi.org/10.1007/s13225-023-00523-6
- Shu, Y., Cheng, R., Huang, J., Li, K., Zhao, S., Zhao, H., Dong, W., Dong, Z., Doilom, M. & Xu, B. (2023) Introducing Nigrograna wuhanensis sp. nov. (Nigrogranaceae, Pleosporales) from Camellia japonica in China. Chiang Mai Journal of Science 50 (3): e2023025.
- Tamura, K., Stecher, G. & Kumar, S. (2021) MEGA11: Molecular Evolutionary Genetics Analysis Version 11. Molecular Biology and Evolution 38 (7): 3022–3027. https://doi.org/10.1093/molbev/msab120
- Tibpromma, S., Hyde, K.D., Jeewon, R., Maharachchikumbura, S.S.N., Liu, J.K., Bhat, D.J., Jones, E.B.G., McKenzie, E.H.C., Camporesi, E., Bulgakov, T.S., Doilom, M., de Azevedo Santiago, A.L.C.M., Das, K., Manimohan, P., Gibertoni, T.B., Lim, Y.W., Ekanayaka, A.H., Thongbai, B., Lee, H.B., Yang, J.B., Kirk, P.M., Sysouphanthong, P., Singh, S.K., Boonmee, S., Dong, W., Raj, K.N.A., Latha, K.P.D., Phookamsak, R., Phukhamsakda, C., Konta, S., Jayasiri, S.C., Norphanphoun, C., Tennakoon, D.S., Li, J., Dayarathne, M.C., Perera, R.H., Xiao, Y., Wanasinghe, D.N., Senanayake, I.C., Goonasekara, I.D., de Silva, N.I., Mapook, A., Jayawardena, R.S., Dissanayake, A.J., Manawasinghe, I.S., Chethana, K.W.T., Luo, Z.L., Hapuarachchi, K.K., Baghela, A., Soares, A.M., Vizzini, A., Meiras-Ottoni, A., Mešić, A., Dutta, A.K., de Souza, C.A.F., Richter, C., Lin, C.G., Chakrabarty, D., Daranagama, D.A., Lima, D.X., Chakraborty, D., Ercole, E., Wu, F., Simonini, G., Vasquez, G., da Silva, G.A., Plautz Jr., H.L., Ariyawansa, H.A., Lee, H., Kušan, I., Song, J., Sun, J., Karmakar, J., Hu, K., Semwal, K.C., Thambugala, K.M., Voigt, K., Acharya, K., Rajeshkumar, K.C., Ryvarden, L., Jadan, M., Hosen, M.I., Mikšík, M., Samarakoon, M.C., Wijayawardene, N.N., Kim, N.K., Matočec, N., Singh, P.N., Tian, Q., Bhatt, R.P., de Oliveira, R.J.V., Tulloss, R.E., Aamir, S., Kaewchai, S., Marathe, S.D., Khan, S., Hongsanan, S., Adhikari, S., Mehmood, T., Bandyopadhyay, T.K., Svetasheva, T.Y., Nguyen, T.T.T., Antonín, V., Li, W.J., Wang, Y., Indoliya, Y., Tkalčec, Z., Elgorban, A.M., Bahkali, A.H., Tang, A.M.C., Su, H.Y., Zhang, H., Promputtha, I., Luangsa-ard, J., Xu, J., Yan, J., Ji-Chuan, K., Stadler, M., Mortimer, P.E., Chomnunti, P., Zhao, Q., Phillips, A.J.L., Nontachaiyapoom, S., Wen, T.C. & Karunarathna, S.C. (2017) Fungal diversity notes 491–602: Taxonomic and phylogenetic contributions to fungal taxa. Fungal Diversity 83: 1–261. https://doi.org/10.1007/s13225-017-0378-0
- Treasure, U.N., Christiana, A.C., Maduabuchi, E.P., Nnamdi, O.A., Ebiye, E.C., Chigozie, U.M., Chiedu, O.F.B. & Okechukwu, E.C. (2020) The isolation, identification and antimicrobial activities of endophytic fungi from Azadirachta indica. GSC Biological and Pharmaceutical Sciences 11 (3): 115–124. https://doi.org/10.30574/gscbps.2020.11.3.0171
- Umurhurhu, J., Okezie, U. & Ngwoke, K. (2023) Evaluation of the antimicrobial and antiviral potentials of extracts of endophytic fungi from Azadirachta indica. GSC Biological and Pharmaceutical Sciences 23 (1): 61–66. https://doi.org/10.30574/gscbps.2023.23.1.0078
- Vilgalys, R. & Sun, B.L. (1994) Ancient and recent patterns of geographic speciation in the oyster mushroom Pleurotus revealed by phylogenetic analysis of ribosomal DNA-sequences. Proceedings of the National Academy of Sciences of the United States of America 91: 7832. https://doi.org/10.1073/pnas.91.10.4599
- Vilgalys, R. & Hester, M. (1990) Rapid genetic identification and mapping of enzymatically amplified ribosomal DNA from several Cryptococcus species. Journal of Bacteriology 172: 4238–4246. https://doi.org/10.1128/jb.172.8.4238-4246.1990
- Wanasinghe, D.N., Wijayawardene, N.N., Xu, J., Cheewangkoon, R. & Mortimer, P.E. (2020) Taxonomic novelties in Magnolia-associated pleosporalean fungi in the Kunming Botanical Gardens (Yunnan, China). PLoS ONE 15 (7): e0235855. https://doi.org/10.1371/journal.pone.0235855
- Wang, H.L., Chen, Z.Z., Koski, T.M., Zhang, B., Wang, X.F., Zhang, R.B., Li, R.Q., Wang, S.X., Zeng, J.Y. & Li, H.P. (2024) Emerald ash borer infestation-induced elevated negative correlations and core genera shift in the endophyte community of Fraxinus bungeana. Insects 15 (7): 534.
- Watanabe, M., Yonezawa, T., Lee, K., Kumagai, S., Sugita-Konishi, Y., Goto, K. & Hara-Kudo, Y. (2011) Molecular phylogeny of the higher and lower taxonomy of the Fusarium genus and differences in the evolutionary histories of multiple genes. BMC Ecology and Evolution 11: 322. https://doi.org/10.1186/1471-2148-11-322
- White, T.J., Bruns, T., Lee, S. & Taylor, J. (1990) Amplification and direct sequencing of fungal ribosomal RNA genes for phylogenetics. In: Innes, M.A., Gelfand, D.H., Sninsky, J.J. & White, T.J. (Eds.) PCR protocols: a guide to methods and applications. Academic Press, Cambridge, Massachusetts, USA, pp. 315–322. https://doi.org/10.1016/B978-0-12-372180-8.50042-1
- Xu, R.F., Karunarathna, S.C., Phukhamsakda, C., Dai, D.Q., Elgorban, A.M., Suwannarach, N., Kumla, J., Wang, X.Y. & Tibpromma, S. (2024) Four new species of Dothideomycetes (Ascomycota) from Pará Rubber (Hevea brasiliensis) in Yunnan Province, China. MycoKeys 103: 71–95. https://doi.org/10.3897/mycokeys.103.117580
- Zhang, Z.Y., Pan, H., Tao, G., Li, X., Han, Y.F., Feng, Y., Tong, S.Q. & Ding, C.Y. (2024) Culturable Mycobiota from Guizhou Wildlife Park in China. Mycosphere 15 (1): 654–763. https://doi.org/10.5943/mycosphere/15/1/5
- Zhang, J.F., Liu, J.K., Thambugala, K.M., Yang, J., Meng, Z.H. & Liu, Z.Y. (2020) Two new species and a new record of Nigrograna (Nigrogranaceae, Pleosporales) from China and Thailand. Mycological Progress 19: 1365–1375. https://doi.org/10.1007/s11557-020-01633-0
- Zhao, Y.Z., Zhang, Z.F., Cai, L., Peng, W.J. & Liu, F. (2018) Four new filamentous fungal species from newly collected and hive-stored bee pollen. Mycosphere 9 (6): 1089–1116. https://doi.org/10.5943/mycosphere/9/6/3